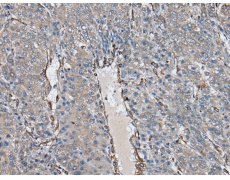
一抗

|
Background: |
Ubiquitin (MIM 191339) is a highly conserved 76-amino acid protein involved in regulation of intracellular protein breakdown, cell cycle regulation, and stress response. Ubiquitin is released from degraded proteins by disassembly of the polyubiquitin chains, which is mediated by ubiquitin-specific proteases (USPs), such as USP25 (Valero et al., 1999 [PubMed 10644437]). |
|
Applications: |
ELISA, IHC |
|
Name of antibody: |
USP25 |
|
Immunogen: |
Fusion protein of human USP25 |
|
Full name: |
ubiquitin specific peptidase 25 |
|
Synonyms: |
USP21 |
|
SwissProt: |
Q9UHP3 |
|
ELISA Recommended dilution: |
5000-10000 |
|
IHC positive control: |
Human liver cancer |
|
IHC Recommend dilution: |
30-150 |

 購(gòu)物車(chē)
購(gòu)物車(chē) 幫助
幫助
 021-54845833/15800441009
021-54845833/15800441009